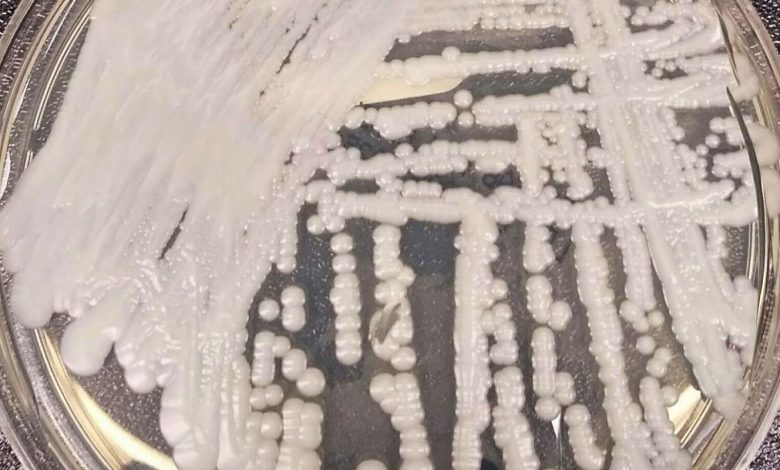

Confirmado segundo caso de Candida auris em PE
A Agência Nacional de Vigilância Sanitária (Anvisa) recebeu a confirmação do segundo caso de Candida auris no país. O “superfungo” foi detectado em um paciente de um hospital em Pernambuco. É o segundo caso confirmado no hospital. Os dois pacientes, um homem de 38 anos e uma mulher de 70 anos, foram isolados no início do mês. No dia 3 de janeiro, a Anvisa foi notificada sobre os casos possíveis de Candida auris, agora confirmados.
De acordo com a Anvisa, o hospital onde os pacientes estão internados estabeleceu medidas de precaução e adotou ações para conter o surto. Além disso, a agência destacou que órgãos de saúde pública foram acionados e ações de vigilância, prevenção e controle foram intensificados.
A Anvisa trata o caso como o terceiro surto do superfungo no país. Segundo a agência, a definição epidemiológica de surto abrange não apenas uma grande quantidade de casos de doenças contagiosas ou de ordem sanitária, mas também o surgimento de um microrganismo novo na epidemiologia de um país ou até de um serviço de saúde. A agência destacou que o fungo significa uma ameaça à saúde global.
Candida Auris
O organismo é chamado de superfungo pela resistência que possui a antibióticos e outras formas de tratamento. De acordo com a Anvisa, o fungo também permanece no ambiente por longos períodos, que podem chegar a meses, e resiste a diversos tipos de desinfetantes.
Por essas razões, casos de infecções pelo fungo trazem risco de surto e demandam monitoramento e medidas de prevenção e controle para impedir a disseminação em outros pacientes.
Conforme nota de alerta da agência, o Candida auris “pode causar infecção na corrente sanguínea e outras infecções invasivas, podendo ser fatal, principalmente em pacientes imunodeprimidos ou com comorbidades”.
Em outubro de 2016, a Organização Pan-Americana da Saúde/Organização Mundial da Saúde (OPAS/OMS) publicou um alerta epidemiológico em função dos relatos de surtos de Candida auris em serviços de saúde da América Latina, recomendando aos Estados-membros a adoção de medidas de prevenção e controle de surtos decorrentes deste patógeno.
No Brasil, o primeiro caso foi registrado em dezembro de 2020 na Bahia. O caso culminou em um surto com 15 casos, resultando em duas mortes. Já em dezembro de 2021, a Anvisa foi notificada de outro caso, também na Bahia, caracterizando o segundo surto.
Fonte: Agência Brasil





